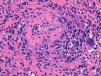

Wegener's granulomatosis (WG) is a necrotizing vasculitis of unknown etiology that involves small and medium caliber vessels. It is associated with anti-neutrophil cytoplasm antibodies (ANCA). It most often affects the respiratory tract and the kidneys and its most important pathologic feature is the presence of necrotizing granulomas.
ObjectivesTo detail the features of 15 patients with WG diagnosed in a university referral center.
Patients and methodsRetrospective study: between 1984 and 2009, 15 patients with WG were diagnosed in our center. Epidemiological, clinical, laboratory tests as well as pathologic studies and treatment were retrospectively analyzed. Biopsy diagnosis of WG was considered as an inclusion criterion.
ResultsFifteen patients were diagnosed: 12 men and 3 women. Mean age at diagnosis: 52.2 years (14–78). Twelve patients had a history of smoking. A biopsy was diagnostic in all patients. ANCA were positive in 11 cases, 6 had a cytoplasmic c-ANCA pattern. All patients had pulmonary involvement and seven (40%) had renal involvement. All patients received intravenous glucocorticoids and cyclophosphamide as induction therapy. During the disease progression 5 patients died.
ConclusionThe clinical features of this series do not differ from those described by other authors. However, a history of smoking is more common than expected. Frequently used drugs were glucocorticoids and cyclophosphamide (oral and pulse therapy). The course was usually unfavorable, with outbreaks or complications due to immunosuppression, except for those with limited forms. Immunosuppressive therapy should be maintained indefinitely in most cases.
La granulomatosis de Wegener (GW) es una vasculitis necrosante de causa desconocida, que afecta a vasos de mediano y pequeño calibre. Se asocia con anticuerpos anticitoplasma de neutrófilo (ANCA). Afecta con más frecuencia a los aparatos respiratorio y renal, y la característica anatomopatológica más relevante es la presencia de granulomas necrosantes.
ObjetivosDetallar las características de una serie de 15 pacientes con GW diagnosticados en un centro universitario de referencia.
Pacientes y métodosDiseño retrospectivo: entre 1984 y 2009 se diagnosticaron 15 pacientes con GW en nuestro centro. De todos ellos se obtuvieron de forma retrospectiva datos epidemiológicos, clínicos, analíticos, estudios anatomopatológicos y tratamiento recibido. Se consideró criterio de inclusión la biopsia diagnóstica de GW.
ResultadosSe diagnosticaron de GW 15 pacientes: 12 hombres y 3 mujeres. Edad media en el momento del diagnóstico: 52,2 años (14-78). Antecedente de tabaquismo: 12 pacientes. Se practicó una biopsia que fue diagnóstica en todos los pacientes. Los ANCA resultaron positivos en 11 casos, y de éstos, 6 correspondían a un patrón citoplasmático c-ANCA. Todos los pacientes tuvieron afectación pulmonar y siete (46%) tuvieron afectación renal. Todos los pacientes recibieron como tratamiento de inducción glucocorticoides endovenosos y ciclofosfamida. Cinco han fallecido.
ConclusionesLas características clínicas de la presente serie no difieren de las descritas por otros autores. El antecedente de tabaquismo fue más frecuente de lo esperado. Los fármacos más utilizados fueron los glucocorticoides y la ciclofosfamida (oral y en emboladas). La evolución generalmente fue desfavorable, con brotes o complicaciones debidas al estado de inmunosupresión, con excepción de las formas localizadas. Es preciso mantener el tratamiento inmunosupresor de forma indefinida en la mayoría de los casos.
Granulomatosis with polyangiitis (GP) is a systemic vasculitis of unknown cause that affects vessels of small and medium caliber. It is characterized by involvement of the respiratory system and kidneys, but can affect other organs also. The anti-neutrophil cytoplasm antibodies (ANCA) are positive and often, the most important histological feature is the presence of necrotizing granulomas. The diagnosis is based on clinical data, biopsy of the affected organs and the presence of ANCA. It is currently grouped within the ANCA positive vasculitis.1–4 This type of vasculitis is rare in Spain and the existing series include a limited number of patients. Here, we describe the clinical, laboratory, imaging data and treatment received in a series of 15 patients with GP diagnosed at a university hospital.
Patients and MethodsWe retrospectively reviewed (1984–2009) the databases of the Department of Rheumatology (CIPP), which recorded all diagnoses made in our section since 1984, and the pathology department of the Hospital Universitari Germans Trias i Pujol that has an area reference of 850,000 inhabitants. In our center, rheumatology reviews the collagen-associated diseases as well as vasculitis, so that patients are studied in our service even without joint manifestations. To complete the series, we included patients studied in other departments such as nephrology and reviewed the database of the pathology department, which classifies patients by pathologic diagnosis. In this period 15 patients were diagnosed with GP. All patients met the classification criteria of the American College of Rheumatology (ACR) and the Chapel Hill Consensus.4–6 Inclusion criteria were the presence of a diagnostic biopsy. We reviewed the physical and electronic medical records of all patients. The following variables were gathered: epidemiological, clinical, imaging, treatment, and laboratory tests such as CBC (Coulter), erythrocyte sedimentation rate (ESR) (Westergren), C-reactive protein (CRP) (nephelometry), plasma and urine biochemistry, as well as ANCA (immunofluorescence with Menarini kits; immunosorbent ELISA Phadia).
ResultsIn this period there were 358 vasculitis diagnosed by the rheumatology department. Forty-four cases belonged to the subgroup of ANCA-associated vasculitis: 16 microscopic polyangiitis, 18 GW and 10 Churg Strauss syndrome. The estimated annual incidence of GW was 0.6 per million inhabitants.
Fifteen patients met histological criteria for GP: 12 males (80%) and 3 women (20%). The mean age at diagnosis was 52.2 years (range 14–78). The mean time from onset of symptoms to diagnosis was 3.5 months (range 0.5–14). The mean follow-up was 82.7 months with a maximum value of 426. Twelve patients (80%) had a history of smoking and snorting cocaine in a habitual way.
The main clinical manifestations are shown in Tables 1 and 2. Half of the patients (53%) had fever as one of the initial symptoms and 40% had constitutional symptoms at the time of hospital admission.7–9 The most frequent clinical manifestations were respiratory involvement. Thirteen had involvement of the upper airway and 11 had pulmonary involvement. Sinusitis was the most common alteration of the upper respiratory tract, observed in 7 patients (46%), followed by rhinorrhea 4 (26%) and nasal crusting 3 (20%). Four patients (26%) had nasal septum perforation during follow-up and two tracheal stenosis, requiring surgery. Cough was the most common respiratory symptom, present in 10 cases (66%), followed by hemoptysis in 5 (33%). Two patients (13%) had an episode of pulmonary hemorrhage. Three cases (20%) had a limited form of GP (two of the upper airway and 1 tracheal).
Main Published Series of Patients With Poliangeitis Granulomatosis (Wegener). Comparison of Clinical, Epidemiological and Immunological Manifestations With Our Series.
| Fauci11 (1983) | Anderson12 (1992) | Hoffman7 (1992) | Tural13 (1992) | González-Gay10 (1999) | Ríos-Blanco14 (2005) | Martínez-Morillo (2010) | |
| Number | 85 | 265 | 158 | 6 | 9 | 13 | 15 |
| Years of inclusion | 21 | 10 | 24 | 5 | 10 | 20 | 25 |
| Mean age | 40.6 | 50 | 41 | 38.3 | 58.4 | 44 | 52.2 |
| Male/female | 48/37 | 146/119 | 79/79 | 5/1 | 3/6 | 10/3 | 12/3 |
| Organ affection | |||||||
| Fever | 34 | – | 23 | 50 | 44 | 61 | 53 |
| Upper airway | 94 | 75 | 92 | 67 | 67 | 77 | 86 |
| Lung | 94 | 63 | 90 | 50 | 78 | 69 | 73 |
| Kidney | 85 | 60 | 77 | 50 | 89 | 61 | 40 |
| Nervous system | 50 | – | 15 | 17 | – | 54 | 53 |
| Cardiovascular | 12 | – | 6 | – | – | 31 | – |
| Skin | 45 | 25 | 46 | 33 | 44 | 23 | 40 |
| Eye | 58 | 14 | 15 | – | – | 15 | 13 |
| ANCA | |||||||
| Positive/investigated | – | – | – | 4/6 | 6/7 | 6/9 | 11/12 |
Summary of the Clinical Manifestation of Patients in the Series.
| Age and Gender | ANCA | Airways | Renal | Skin | Eye | Locomotor | Nervous System |
| 33, male | c-ANCA | Sinusitis, rhinorrea and crusting, cavitated nodules, hemoptisis | Glomerulonephritis | Subcutaneous nodules, ulcers, digital ischemia | Dacriocistitis | Joint pain-arthritis | Multineuritis |
| 38, male | c-ANCA | Granulomas, hemoptisis | Glomerulonephritis | Skin vasculitis | Conjunctivitis | Joint pain | No |
| 45, male | Unknown | Sinusitis | Glomerulonephritis | Skin vasculitis | No | No | Mononeuritis multiple |
| 51, male | c-ANCA | Rhinorrea and crusting, cough, nodules, hemoptisis | Kidney failure | Leucocitoclastic vasculitis | No | No | Multineuritis |
| 60, male | c-ANCA | Sinusitis, cough, nodules | Glomerulonephritis | No | No | No | Multineuritis |
| 58, male | c-ANCA | Rhinorrea | Kidney failure | No | No | No | Mononeuritis multiplex |
| 78, female | c-ANCA | Rhinorrea and crusting | No | Paniculitis | No | No | External ocular motor paralysis |
| 66, male | Negative | Bronchial stenosis, cough, nodules | No | Skin ulcer | No | No | No |
| 60, female | p-ANCA | Rhinorrea and crusting, sinusitis, hemoptisis | No | No | No | No | Sensoryneural Hearing loss |
| 68, male | p-ANCA | Sinusitis, cough, granulomas | No | No | No | No | Hidrocephalus due to plexitis and ependymitis |
| 48, male | c-ANCA | Tracheal stenosis, nodules, hemoptisis | No | No | No | No | No |
| 67, male | c-ANCA | Cough, nodules | No | No | No | No | No |
| 33, female | p-ANCA | Nasal septum destruction | No | No | No | No | No |
| 64, male | Unknown | Sinusitis, cough, nodules, hemoptisis | No | No | No | No | No |
| 14, male | Unknown | Bronchial and tracheal stenosis, rhinorrhea, cough and hemoptisis | No | No | No | No | No |
Neurological involvement was observed in 8 patients (53%) and was second in frequency. In 7 cases (46%) the peripheral nervous system was affected: mononeuritis multiplex,5 abducens palsy1 and sensorineural hearing loss.1 A single patient (6%) had central nervous system involvement as the initial manifestation of the disease, manifested as ependymitis and plexitis and secondary hydrocephalus requiring ventriculostomy and drainage.
Renal involvement was common, seen in 7 patients (46%). All had a necrotizing glomerulonephritis. Five of them (33%) had proteinuria, although only one was in the nephrotic range and 4 had hematuria (26%). Of the 7 patients with renal involvement, 4 progressed to chronic renal failure (26%) and one of them required hemodialysis (6%).
Skin manifestations occurred in 6 patients (40%) 3 had leukocytoclastic vasculitis, 2 had vasculitic ulcers and 1 had panniculitis. Other less affected systems were the eye (2, 13%) and musculoskeletal.2 One patient had conjunctivitis and other had dacryocystitis. Two patients (13%) had joint pain of large joints. Cardiovascular and gastrointestinal involvement was not present.
Regarding imaging, more than half of our patients (10 of 15, 66%) had abnormalities on the chest X-ray. The most common was the presence of pulmonary nodules (80%), followed mainly by bilateral infiltrates (50%). Only one of the patients had pleural effusion. A CT scan was performed in 8 patients, and all confirmed the presence of nodules and in four of them (50%) with cavitation.
Laboratory tests at the time of diagnosis showed that all patients had anemia with a mean hemoglobin level of 10.6g/dl. Seven patients (46.6%) had leukocytosis with an average of 15,400×109, 5 cases (33.3%) had thrombocytosis, with a mean platelet count of 523,000×109/l. The ESR and CRP were elevated in 90% of cases, with an average of 65.3mm/h and 37.6mg/l (No.<5mg/l), respectively. ANCA were positive in 11 cases (73%), negative in 1 case (6.6%) and unknown in 3 cases (20%). Of the ANCA positive, 6 (54%) were c-ANCA with specificity for proteinase 3, 3 (27%) p-ANCA with specificity for myeloperoxidase and the rest unspecified.
Thirty biopsies were performed. Only 21 of them (70%) were compatible with GP, the rest were inconclusive. The most commonly biopsied organ was the lung: 5 biopsies. Four showed necrotizing granulomatous pneumonitis with small and medium caliber vessel vasculitis. Five biopsies were performed in the nostrils. Three of them showed necrotizing vasculitis with granulomas. The remaining 2 showed granulation tissue with fibrinoid necrosis in vessels of small and medium caliber, with no granulomas. Regarding airway biopsies (a total of 4), granulomatous tracheitis was observed in 2 performed in the trachea and necrosis with granulation tissue with abundant histiocytes and multinuclear cells in 2 bronchial samples (Fig. 1). Four renal biopsies were performed. All of them showed necrotizing vasculitis, two with extracapillary proliferation. There was no evidence of granulomas. Two patients underwent a skin biopsy of purpuric lesions. One showed a leukocytoclastic vasculitis and other a granulomatous vasculitis with epidermal ulceration. One patient was diagnosed with multiple mononeuritis and a muscle biopsy showed vasculitis with fibrinoid necrosis of muscle arterioles. Of the biopsies that were inconclusive or nonspecific, 3 belonged to the lung, 2 the airway, 3 were nasal and 1 of the sural nerve.
All patients received induction therapy with intravenous glucocorticoid at a dose of 1mg/kg/day and cyclophosphamide. In 7 cases (46%), glucocorticoids were administered as a bolus of 0.5–1g cyclophosphamide in 4 cases (26%) was administered intravenously and in 11 (74%) cases, orally in doses of 2mg/kg/day. Treatment during the maintenance phase was conducted with glucocorticoids,7 mycophenolate mofetil,4 rituximab2 and azathioprine.2 One of the patients had a relapse of renal involvement, requiring plasmapheresis. At present, we have followed 7 patients (46%). Two remain with immunosuppressive therapy and 5 are treated with mycophenolate mofetil at an average dose of 810mg/day4 and azathioprine in doses of 150mg/day.1 Five are simultaneously receiving glucocorticoids in doses that average 3mg/day (2.5–10). Two patients required surgical intervention for upper airway stenosis and one patient was treated with hemodialysis. Five died from complications of the disease or immunosuppressive therapy.
DiscussionGP is a rare entity. The annual incidence in our area of reference is 0.6 cases per million inhabitants. This explains the limited number of patients seen in a single hospital over a period of 25 years. This contrasts with the higher incidence found by González-Gay et al.10 (Lugo), who described 9 patients over 10 years. These differences could be due to the fact that in our reference area there are several regional hospitals to which patients could go, or the strictness of our criteria for inclusion.
The demographic characteristics are similar to those of other series7,10–14 Notably, a higher prevalence of smoking among the patients studied, which reaches 80%, something not reported in any of the other series. The prevalence of smokers in Spain is between 29% and 34%. Most patients were men, which contrasts with data from other series that show no significant differences in gender or describing a slight predominance in males. The average age of presentation coincides with the rest of the series, around the fourth or fifth decade of life.7,10–14
Particularly striking is the low incidence of cardiovascular involvement in the Spanish series compared to Ríos-Blanco et al.14 However, in the other series there are also similar rates of cardiovascular involvement. Another important characteristic is the increased prevalence of neurological and kidney involvement not seen in other series. The rest of the clinical manifestations are often similar to that observed in other published series, with airway involvement being the most frequent.7,10–14
In terms of imaging abnormalities described, the most common in chest radiographs and computed tomography were nodules (50% of the cases were cavitated) and infiltrations, data that do not differ from those in other series.7,10
The determination of ANCA is an important diagnostic test, although not included in the ACR classification criteria4 or the Chapel Hill Consensus.6 It is estimated that the diagnostic sensitivity of c-ANCA is 66% and specificity 98%. As other studies show, the presence of positive ANCA is very common, between 85% and 91% of patients. It also demonstrates the predominance of cytoplasmic (6 of 11) over the perinuclear (3 of 11) pattern.7,13,14
A total of 30 biopsies were performed in 15 patients. Only 21 of these found alterations compatible with GP. Of the biopsies that were inconclusive or nonspecific, 3 belonged to the lung, 3 to airway passages 3 and 1 to the sural nerve. All renal biopsies performed were diagnostic and showed no granulomas. This is consistent with the data described by Davaney et al.15 who consider transbronchial lung and nasal biopsies of low yield. However, renal biopsies are very productive, although rarely show evidence of granulomas.
The standard treatment of GP during the induction phase is a combination of glucocorticoids at a dose of 1mg/kg/day and cyclophosphamide orally or intravenously. All patients received this treatment. For the maintenance phase there are many more differences. Patients received glucocorticoids alone or in combination with mycophenolate mofetil (4), rituximab (2) and azathioprine (2).
The limitations of this study are its retrospective nature and the limited number of patients leading to the low incidence of this disease.
In conclusion, there were a total of 15 patients diagnosed with GP. The clinical characteristics of this series do not differ from those reported by other authors. Note the frequency of smoking, not referenced in other series. ANCA were positive in 91% of patients. The drugs used in the treatment of GP were glucocorticoids and cyclophosphamide. The outcome was unfavorable, with relapses or complications due to immunosuppression, with the exception of localized forms. It was necessary to maintain the immunosuppressive therapy indefinitely in most cases.
Conflict of InterestThe authors declare that there is no conflict of interest.
Please cite this article as: Martínez-Morillo M, et al. Granulomatosis con poliangeítis (Wegener). Descripción de 15 casos. Reumatol Clin. 2012;8(1):15–19.